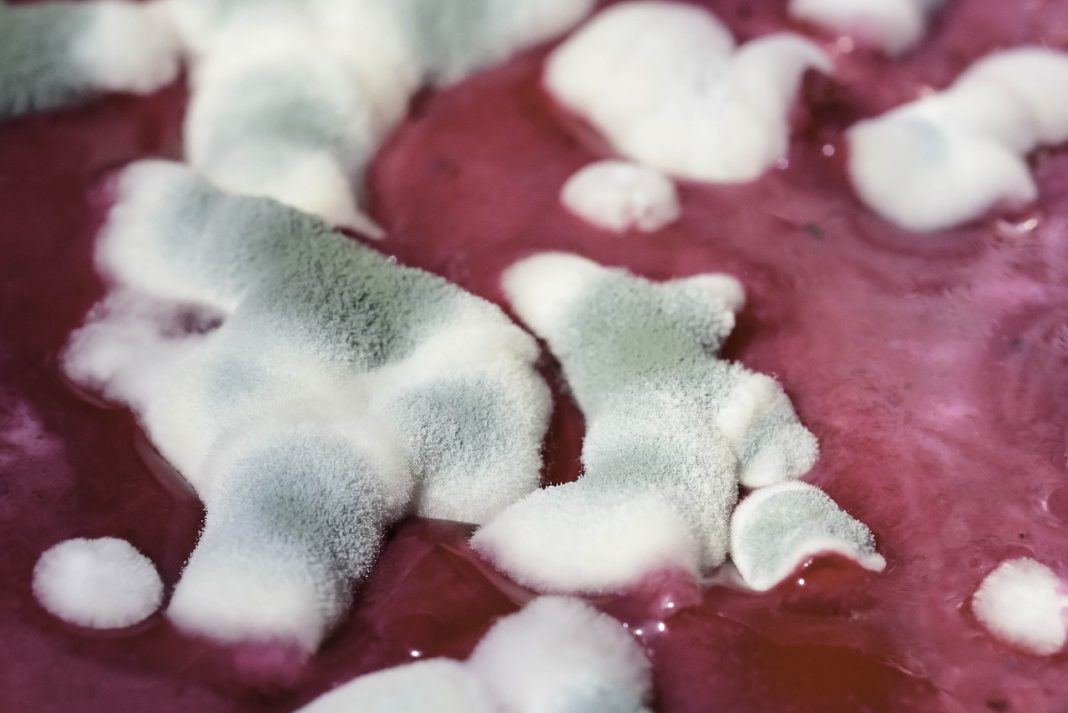
moho

El pollo es uno de los alimentos más versátiles, nutritivos y también deliciosos. Son muchos los beneficios que aporta a la salud y es apto para todos en el hogar; sin embargo, su manejo, proceso de conservación, forma de cocción y consumo es muy delicado. Así como es importante congelarlo y descongelarlo de la manera correcta y cocinarlo perfectamente bien, consumirlo en buen estado es la única opción para que su consumo sea seguro.
9Reacciones causadas por el moho
En caso de inhalar moho, puedes desarrollar afecciones respiratorias que pueden tornarse peligrosas; de igual forma si lo consumes, se abre paso a trastornos digestivos como diarreas y vómitos, que de no ser atendidos pueden causar deshidratación y complicaciones importantes.
El mayor riesgo lo representan las micotoxinas, estas son sustancias tóxicas producidas por algunos tipos de hongos Aspergillus, Fusarium y Penicillium, son las más importantes. Estas toxinas cuentan con estabilidad térmica y no desaparecen durante el cocinado.
